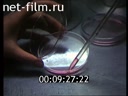
Footage frame

For schoolchildren. Generalization of modern ideas about the evolution of species and the origin of man.

People on the street.
A monkey in a cage.
Animals in a zoo.
A portrait of Charles Darwin on the flyleaf of his book.
The Royal Ship Beagle (a drawing from a book).
Drawings in Darwin's book.
Lecture, one of the students fell asleep.
Rock paintings.
Paintings by artists: C.-J. Vernet "The Park of the Villa Pamphili"; C. Monet "Breakfast on the Grass"; O. Renoir "Bathing in the Seine"; J. Seurat "Sunday on the Island of La Grande Jatte", P. Signac "Pine Tree in Saint-Tropez".
Portrait of N. Lobachevsky.
Imprints of ancient plants.
Fossilized remains of ancient organisms.
Portrait of Darwin.
Portrait of G. Mendel.
DNA structure (animation).
Cell division (animation).
Fertilization (animation).
Photographs of cells.
Professor V. M. Buren gives a lecture.
Experiments in the laboratory.
Cells under a microscope.
A wounded starfish heals its wound.
Skeletons of ancient animals in the museum.
Landscapes.
Bumblebee on a flower.
Bird colony.
Sea urchins.
Common hedgehog.
Black hedgehog in a laboratory.
People with their pets in a queue to see a veterinarian.
A doctor examines a cat.
Fruit fly mutants.
Experiments with mice in a laboratory.
A blood cell under a microscope.
A monkey in a cage.
Silver-black foxes in an enclosure.
Fox cubs in a cage.
Fur farm.
Stuffed foxes of different colors in a museum.
Photo by geneticist N. Timofeev-Resovsky.
Laboratory.
Streets of St.
Petersburg.
Waves splashing on the shore.
Mountains.
Evolution, Paleontology
Autumn